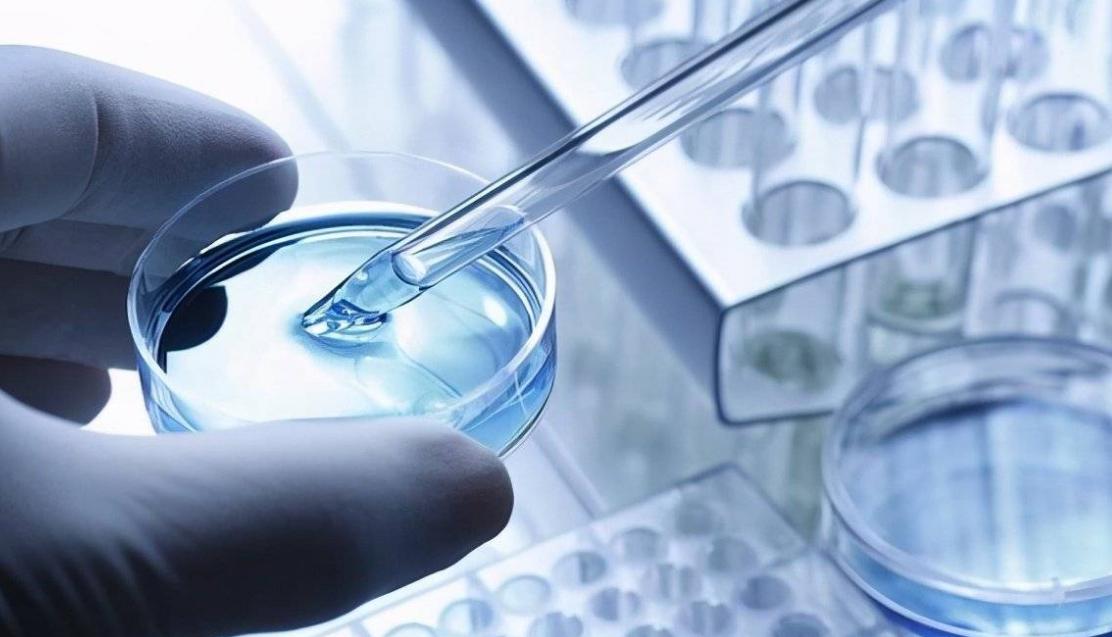
抗癌最新突破消息治肺癌,抗癌最新突破

2022年2月,51岁的董阿姨不幸患上了子宫鳞状细胞癌,并且检查发现已经是IIIC1r,即中晚期。心急如焚的董阿姨听取医生的建议进行了放化疗。
可是随着化疗时间一长,董阿姨出现了严重的消化道反应,这让她的心情也变得异常糟糕,于是拒绝了后续的化疗方案。但幸运的是,当前出现了一种新型治疗肿瘤的方式——自体肿瘤浸润淋巴细胞治疗,即TIL治疗。
听到此消息的董阿姨遂自愿参加此项治疗。之后,她在7月开始TIL治疗,并于8月辅以两次PD-1单抗免疫治疗。

可喜的是,此疗法的效果甚至出乎董阿姨本人的预料。她在输注完TIL细胞不久后就感到之前的消化道不适症状有明显的改善。两个月后,在她复查全腹部磁共振时更是被诊断为完全缓解,即其子宫内的肿瘤已经完全消失、以至于在影像学检查中完全观察不出来了。
董阿姨的治愈经历也成为国内第一例经TIL疗法实现的肿瘤完全缓解。那么什么是TIL疗法呢,它真的有这么神奇吗?
一、TIL疗法是什么?
TIL全称是肿瘤浸润淋巴细胞, 也就是指肿瘤组织中的淋巴细胞 ,该细胞在肿瘤组织里经过多种因素的刺激发生活化、成熟,会产生一定比例的具有*伤杀**癌细胞功能的T细胞。

因此科学家就根据这一特点,对组织内具有*伤杀**肿瘤作用的TIL细胞进行分离、提取、基因工程改造和体外扩增,将原来病人组织内一小部分的细胞培养成一定数量的具有治疗效果的TIL细胞,然后回输进病人体内,以达到抗肿瘤目的。
而TIL细胞几乎在所有的实体肿瘤生长中均发挥着控制作用, 它能够识别肿瘤、增强肿瘤组织发生炎症、坏死反应, 所以它的*伤杀**作用具有特异性和高效性的特点。
在回输进病人体内后,TIL细胞能迅速聚集在肿瘤周围,分泌杀灭肿瘤细胞的因子,如穿孔素等;同时还可以激活已有的免疫系统,募集更多的免疫细胞前来一起*伤杀**肿瘤细胞。

并且由于TIL细胞属于T细胞, 具有较持久的免疫力,因此经过TIL治愈的患者,即使肿瘤消失后TIL仍可长期驻存, 甚至可以达到数十年的完全缓解。
并且该疗法完全是采用病人自己的T细胞,所以安全性有很高的保障,极少出现不良反应。
TIL可以治疗晚期不可手术的肿瘤患者,这对于许多绝望的病人来说无疑是一种“救命药”,病例中的董女士正是这样的情况。但事实上,TIL疗法作为早期可手术患者的辅助治疗方式效果更佳。那么它适用于哪些肿瘤类型呢?
二、TIL与之前大火的CAR-T疗法有哪些不同?
不久前,CAR-T备受关注,它在应用于B细胞淋巴瘤时效果极佳。 而TIL与CAR-T相似,都属于T细胞免疫治疗, 因此 专家将它们两者形象地称为“姊妹药”, 但它们两者也有明显的不同。

首先是来源不同。CAR-T细胞来源于外周血的T细胞,因此它多用于血液系统肿瘤;而TIL细胞则来自肿瘤组织内部,对大多数实体肿瘤具有较好疗效。
其次是,安全性方面有较大差异。CAR-T属于人工设计的细胞产物,具有高风险性,可以导致患者体内细胞因子风暴等危险性;而TIL细胞完全是患者的自体细胞,没有经过人工修饰, 属于低风险产品。
并且,CAR-T已经是上市产品,价格高达120万元;而TIL则还未有上市过,但采用的国产化设备和原材料,既有技术上的创新,也有成本和制备周期的精进,因此专家估计其成药价格会比CAR-T低许多。
那么除了董阿姨的子宫癌可以使用TIL疗法外,还有哪些肿瘤可以使用它呢?

三、TIL疗法适用于哪些肿瘤?
目前TIL疗法专门在实体肿瘤中应用,即理论上凡是形成可取样的癌组织的肿瘤类型均可以用。据最新文献显示,目前美国公司基于TIL疗法的生物制剂LN-144已经在黑色素瘤、乳腺癌、宫颈癌等肿瘤中显示出较好的疗效。
1.黑色素瘤
复发难治性黑色素瘤是TIL疗法应用最多的领域。目前已有数个TIL疗法相关的产品向美国FDA提供注册申请,同时科学家也开展TIL与程序性死亡受体-1/程序性死亡配体-1(PD-1/PD-L1)的联合治疗方案,为黑色素瘤的治疗提供更多可行性方针。

2.乳腺癌
乳腺癌主要分为Luminal A型、Luminal B型、三阴性型和其他类型。其中三阴性型由于没有特异的治疗靶点,并且肿瘤侵袭性很强,一度令许多患者治愈的希望渺茫,但好在TIL疗法的出现解决了这一个难题。
除此之外, TIL还可以作为乳腺癌预后的强预测因子, 三阴性乳腺癌中TIL浸润水平越高,则患者预后越好,并且患者的生存期也更长。这也提示了TIL疗法不同于常见的放化疗,它对患者的预后是有很大好处的。
3.妇科恶性肿瘤
已经有研究证明TIL疗法对人类乳头状瘤病毒引起的宫颈癌具有治疗作用,除此以外,TIL疗法在卵巢癌和子宫癌中也有强大的治疗潜力,正如病例中的董阿姨就是采用TIL疗法取得了显著的效果。 并且研究表明,TIL也是卵巢癌和子宫内膜癌预后的可靠预测指标。

那么看起来如此特效的TIL疗法,真的是抗肿瘤的完美药物吗?
四、TIL疗法面临的问题?费用多少?
TIL作为效应细胞来自患者体内,功能是直接参与肿瘤抑制,这对于实体肿瘤而言是十分有前景的治疗策略。但是目前TIL疗法仍然面临着诸多挑战。
1.效果虽好,但价格高昂
作为针对患者的个体化治疗措施,TIL的生产和制备需要严格的规范和专业化要求,因此其治疗成本高昂,生产周期也比较长,这对于大部分癌症患者的经济和身体状况而言是个挑战,无法满足患者快速进展的病情,所以在临床应用上备受限制。
据有关研究显示, 2025年我国将上市首个TIL疗法产品,药物价格可能处于60~80万的范围内, 这对大众的接受程度而言是不小的冲击。但“一分钱一分货”的道理也表明TIL疗法的巨大抗癌潜力。
2.在体内起效仍不稳定
TIL的高效提取、培养肿瘤微环境内的TIL并扩增至临床治疗所需的细胞数量,并最终在病人体内发挥良好疗效也是一个难题。通常,只有TIL含有高CD8/CD4比例的T细胞才具有明显效果,因此在培养时需要增加特异性的TIL细胞。

TIL发挥作用的前提是必须到达患者的肿瘤部位, 因此如何使TIL细胞归巢肿瘤、活化的T细胞能否有效穿透至肿瘤实质都是TIL治疗中时刻需要考虑的关键因素。科学家在部分肿瘤治疗的研究中发现,回输的TIL细胞仅有1~2%真正浸润到肿瘤组织中,因此这也是目前亟需解决的问题。
此外, 体外扩增的TIL细胞回输进体内的持久性也有待进一步研究 。因为TIL细胞在外界环境中克隆增殖并没有诸多体内因素的影响,很可能在患者疾病进展过程中,其血液或肿瘤中已经出现新的细胞亚型,这时原先培养的TIL细胞可能就已经缺乏特异性需要及时更新了。

3.并非所有肿瘤均有效
TIL疗法的前提条件是能取到患者的肿瘤组织, 因此仅限于实体肿瘤的治疗 。而一些血液系统的恶性肿瘤,比如淋巴瘤、白血病等非实体瘤就不能适用。
但即使能取到肿瘤组织, 也并非全部的实体肿瘤均可以使用TIL治疗 。比如目前的癌中之王——胰腺癌,正因为它的细胞变异性太强,所以TIL疗法往往来不及应对。除此以外, 在胃癌、泌尿系统肿瘤众TIL疗法也尚未获得理想效果。
从这里我们可以明白,董阿姨的子宫内膜癌属于实体肿瘤, 而且已经属于不能手术的晚期病例 ,因此她使用TIL疗法属于明智之举,并且由于我国TIL疗法还不太成熟,因而她联合使用了PD-1类药物,这样就能尽可能使治疗效果更佳。

并且董阿姨的结果也显示其肿瘤进展得到了很好的控制,基本上没有新生肿瘤的形成,这也说明了TIL疗法的预后十分好。
参考文献
[1]《全国首例TIL疗法癌症治愈病例亮相天津》.每日新报.2022, 12: 12.
[2]倪娜,潘雪君,赵霞,兰志龙,黄宇等. 肿瘤浸润淋巴细胞免疫治疗的临床研究进展[J]. 医药专论,2023, 44: 2.